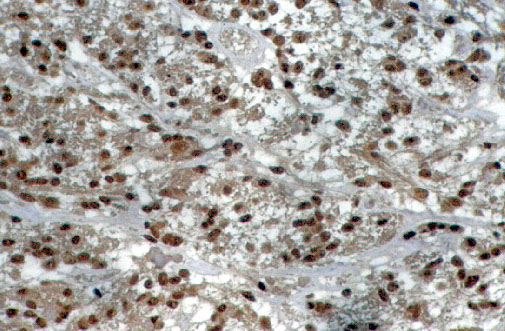
fig. 6

Comunicaciůn
Nļ 071
Comunicaciůn |
Teresa Ribas AriŮo, Elena GarcŪa Lagarto, Francisco Miguel Izquierdo GarcŪa, Santos Salas Valiťn, Ńngela Miguelez Simůn.
 |
| Fig.5: Aspecto multiquŪstico y laxo. H&Ex 20. |
|
| Fig.6: Positividad para la NSE en las cťlulas oligodendrocito-like, NSEx40. |
 |
| Fig.7: Positividad para Leu-7 en las mismas cťlulas. Leu-7x100. |